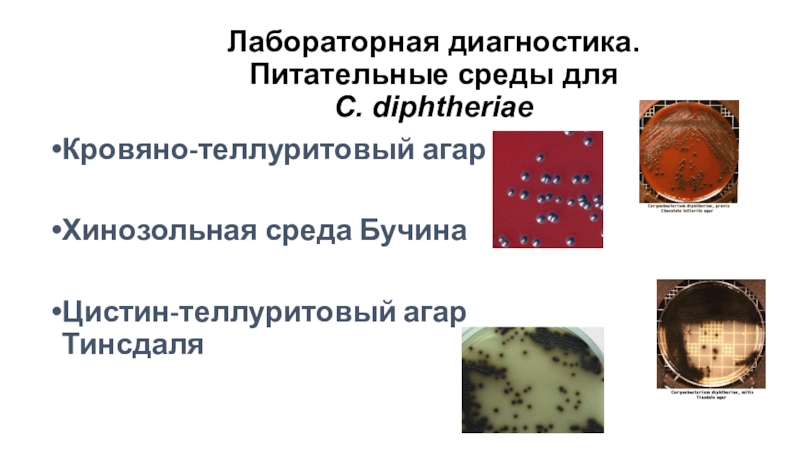
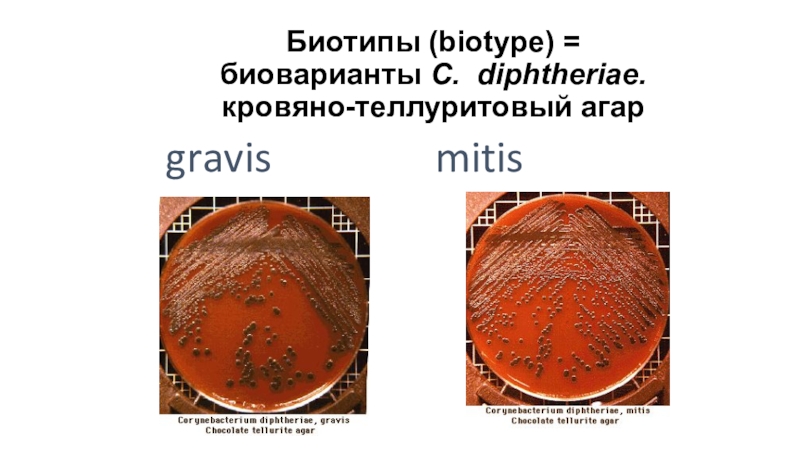

Разделы презентаций
- Разное
- Английский язык
- Астрономия
- Алгебра
- Биология
- География
- Геометрия
- Детские презентации
- Информатика
- История
- Литература
- Математика
- Медицина
- Менеджмент
- Музыка
- МХК
- Немецкий язык
- ОБЖ
- Обществознание
- Окружающий мир
- Педагогика
- Русский язык
- Технология
- Физика
- Философия
- Химия
- Шаблоны, картинки для презентаций
- Экология
- Экономика
- Юриспруденция
Воздушно-капельные инфекции
Содержание
- 1. Воздушно-капельные инфекции
- 2. ЗаболеванияДифтерияКоклюшЛегионеллез
- 3. Возбудитель дифтерииCorynebacterium diphtheriae
- 4. Дифтерия – инфекционное заболевание, характеризующееся синдромом общей
- 5. Таксономия рода Corynebacterium1. C. diphtheriae - типовой
- 6. МорфологияГрамположительные палочки с утолщениями на концах,
- 7. Процент не привитых от дифтерии
- 8. Факторы патогенностиПили и микрокапсула обеспечивают адгезию к
- 9. Клинические проявления дифтерииДифтерийные пленкиДифтерия гортани
- 10. Дифтерийный гистотоксинГистотоксин состоит из двух субъединиц: токсического
- 11. ЭпидемиологияИсточник – больной или бактерионосительПуть передачи –
- 12. Патогенез дифтерииПосле адгезии на клетках слизистой начинается
- 13. Больной дифтерией
- 14. Лабораторная диагностика дифтерии Клинический материал: мазок из зева,
- 15. Бактериологический метод1 этап: посев клинического материала на
- 16. Лабораторная диагностика. Питательные среды для C. diphtheriaeКровяно-теллуритовый агарХинозольная среда БучинаЦистин-теллуритовый агар Тинсдаля
- 17. Биотипы (biotype) = биоварианты C. diphtheriae. кровяно-теллуритовый
- 18. Чувствительность к АМ препаратам:ПенициллинЭритромицинХлорамфениколГентамицинСтрептомицинТетрациклин
- 19. Лечение: Введение антитоксической противодифтерийной сыворотки, не дожидаясь результатов микробиологического анализа.
- 20. Действующее начало
- 21. Специфическая профилактикаТетрАкт-ХИБ Адсорбированная вакцина против дифтерии, столбняка,
- 22. Проба Шика проводится для оценки состояния
- 23. Коклюш – острое инфекционное высококонтагиозное заболевание, характеризующееся
- 24. Возбудитель коклюша – был открыт в
- 25. Таксономия рода BordetellaB. pertussisB. parapertussisB. bronchiseptica
- 26. МорфологияМелкая, овоидная, грам- палочка с закругленными концами Неподвижны. Спор нет. Жгутиков нет. Образует капсулу, пили.
- 27. Резистентность Очень неустойчива во внешней среде. Быстро
- 28. Слайд 28
- 29. Слайд 29
- 30. Слайд 30
- 31. АдгезияФиламентозный гемагглютинин -крупный белок, образующий филаментозные
- 32. Агглютиногены тесно связаны с белками фимбрийИммунизация фимбриальными
- 33. Токсины Bordetella pertussis Аденилатциклаза – единый полипептид
- 34. Приводит к накоплению нейтрофилов в жидкости и
- 35. Трахеальный цитотоксин- фрагмент пептидогликана клеточной стенкиПовреждает ресничный
- 36. ЛипополисахаридОтличается от ЛПС энтеробактерийлипид определяет биологическую активность
- 37. Коклюшный токсинОпосредует как стадию колонизации, так и
- 38. Накопление цАМФ приводит к:Подавлению всех стадий фагоцитоза,Нарушению
- 39. У современных штаммов B.pertussis произошли существенные изменения
- 40. Коклюш - высококонтагиозное заболевание, к которому очень
- 41. Лабораторная диагностикаКлинический материал собирают - сухим
- 42. Бактериологический метод Цель бактериологического исследования:Выделение чистой культуры
- 43. Питательные среды для культивирования бордетеллСреда Борде-Жангу (картофельно-глицериновый
- 44. Величина колоний через 72 чB. pertussis
- 45. Биохимические свойства
- 46. Чувствительность к антимикробным препаратамЭритромицинАмпициллин Профилактика - Вакцинация:1-
- 47. Вакцина против коклюшаАКДС А-адсорбированная К-коклюшно -Д-дифтерийно -С - столбнячная
- 48. Ацеллюлярные вакциныКомпоненты B.pertussis :филаментозный гемагглютинин, пертактин, фимбрии,
- 49. Название заболевания связано со вспышкой 1976 г в Филадельфии тяжёлого респираторного
- 50. Особенности экологии легионелл и их роль в
- 51. Классификация по характеру приобретения инфекции:
- 52. Наиболее типичные эпидемии легионеллеза
- 53. Возбудители тяжелых внебольничных пневмоний
- 54. Фактроры риска:Лица, старше 60 летДлительно курящиеАлкоголикиИммунодефициты: первичные
- 55. Нозокомиальные вспышки легионеллеза (ИС Тартаковский и др., 2010 г)
- 56. Клинические особенности вспышек болезни легионеров (%)
- 57. СинуситыЦеллюлитыПеритонитыПиелонефритыПанкреотитыРаневые инфекцииЛимфааденопатииМиокардитыПерикардитыЭндокардиты искуственных клапановПосткардиотомический синдромЭкстрапульмональные проявления легионеллеза
- 58. Предупреждение госпитального инфицированияИспользование стерильной воды для небулайзеров
- 59. Концентрации легионелл, которые представляют эпидемическую опасность (ИС Тартаковский и др., 2010 г)
- 60. Спасибо за внимание!
- 61. Скачать презентанцию
Слайды и текст этой презентации
Слайд 4Дифтерия – инфекционное заболевание, характеризующееся синдромом общей интоксикации с преимущественным
Слайд 5Таксономия рода Corynebacterium
1. C. diphtheriae - типовой вид
2. C. ulcerans
3.
C. pseudotuberculosis
4. C. striatum
5. C. minutissimum
6. C. xerosis
7. C. pseudodiphtheriticum
Слайд 6Морфология
Грамположительные палочки с утолщениями на концах,
- располагаются в виде
V - неподвижны - многослойная клеточная стенка содержит миколовую кислоту,
корд-фактор - при окраске по Леффлеру и Нейссеру выявляются включения волютина на полюсах клеткиСлайд 8Факторы патогенности
Пили и микрокапсула обеспечивают адгезию к эпителиоцитам миндалин, реже
гортани, трахеи, полости носа, конъюнктивы глаза, вульвы;
колонизация эпителиоцитов сопровождается развитием
воспалительного процесса;Гиалуронидаза, нейраминидаза,гемолизин – факторы инвазии;
микрокапсула – антифагоцитарный фактор;
Корд-фактор – нарушает дыхание в митохондриях и обладает антфагоцитарной активностью;
Дифтерийный гистотоксин – главный фактор патогенности
Слайд 10Дифтерийный гистотоксин
Гистотоксин состоит из двух субъединиц: токсического полипептида (А) и
транспортного полипептида (В), ответственного за доставку токсического компонента к клеткам-«мишеням».
Образование первого контролируется бактериальными генами, второго - генами фага, лизогенизировавшего бактериальную клетку;Только лизогенные бактерии, содержащие tox-ген, полученный в результате фаговой конверсии, патогенны
Фиксация гистотоксина происходит на рецепторах мембран мышечных клеток сердца, паренхимы сердца, почек, надпочечников, нервных ганглиев.
После проникновения в клетку субъединица А взаимодействует фактором элонгации ЕF-2 и осуществляет его АДФ-рибозилирование. При этом блокируется синтез белка на рибосомах, что, в конечном итоге, приводит к гибели клеток.
Слайд 11Эпидемиология
Источник – больной или бактерионоситель
Путь передачи – воздушно-капельный, входные ворота
– носоглотка;
Существенно меньшее значение играют больные дифтерией глаз, кожи, раны
и других локализаций, способные распространять инфекцию контактным путем (через руки, предметы быта, игрушки); Дифтерийные бактерии значительно устойчивы во внешней среде. В дифтерийной пленке, в капельках слюны, на ручках дверей, детских игрушках сохраняются до 15 дней. В пыли, на полу, на предметах в окружении больного дифтерийная палочка сохраняет жизнеспособность до 18-40 дней В воде и молоке выживают в течение 6-20 дней. Хорошо переносят высушивание.
Неблагоприятно на них действуют прямые солнечные лучи, высокая температура. При кипячении погибают в течение 1 мин, очень чувствительна ко всем дезинфицирующим средствам
Коринебактерии дифтерии чувствительны к действию многих антибиотиков: пенициллина, эритромицина, тетрациклина, рифампицина. Однако в носоглотке больных и носителей, несмотря на лечение антибиотиками, бактерии дифтерии могут сохраняться длительное время.
Слайд 12Патогенез дифтерии
После адгезии на клетках слизистой начинается колонизация
Под действием гиалуронидазы,
нейраминидазы осуществляется разрушение межклеточного вещества,
В результате действия гемолизина, корд-фактора и
гистотоксина возникают некроз поверхностного эпителия, в результате развития воспалительного процесса повышается проницаемость сосудов, замедляется кровоток, сосуды становятся ломкими. Жидкая часть крови выходит в окружающие ткани. Фибриноген, содержащийся в плазме, при контакте с тромбопластином некротизированного эпителия переходит в фибрин, который выпадает в виде фибринозной пленки. В области многослойного плоского эпителия , развивается дифтеритическое воспаление, при котором фибринозный выпот, пронизывая всю слизистую оболочку, плотно спаян с подлежащей тканью. На слизистых оболочках с однослойным эпителием (гортань, трахея, бронхи) развивается крупозное воспаление, при котором пленка легко отделяется. Возбудитель остается в месте входных ворот, а в кровь поступает токсин -токсинемия
Наиболее чувствительными к действию токсина являются миокард, капилляры и нервные клетки. В кардиомиоцитах развиваются явления миокардиодистрофии с последующим их некрозом, миолизом и развитием инфекционно-токсического миокардита. Поражение капилляров при дифтерии сопровождается инфекционно-токсическим шоком. Повреждение нервных клеток сопровождается дистрофическими изменениями швановских клеток и демиэлинизацией нервных волокон. Наряду с отмеченным, общее действие дифтерийного токсина проявляется явлениями общей интоксикации.
Таким образом, дифтерийный гистотоксин оказывает местное и общее воздействие на организм
Слайд 14Лабораторная диагностика дифтерии
Клинический материал: мазок из зева, слизь из носоглотки
и др.
Методы:
Бактериоскопический (окраска мазка поЛеффлеру и Нейссеру – предварительный)
Бактериологический
(культуральный) - основнойСерологический (ИФА, латексагглютинация, реакция нейтрализации антител,РНГА) для обнаружения антител и/или токсина в сывороткекрови
ПЦР
Проба Шика – реакция нейтрализации токсина in vivo
Слайд 15Бактериологический метод
1 этап: посев клинического материала на кровяной теллуритовый агар
(среда Клауберга).
2 этап: Макроскопическое изучение колоний, мазок по Леффлеру
или Неййсеру; отсев типичной колонии на среды Ру или Леффлера3 этап: Идентификация по совокупности свойств: культуральных, морфологических, тинкториальных, биохимических, обязательно определение токсигенности методом Оухтерлони; чувствительности к антибиотикам.
Слайд 16Лабораторная диагностика. Питательные среды для
C. diphtheriae
Кровяно-теллуритовый агар
Хинозольная среда Бучина
Цистин-теллуритовый
агар Тинсдаля
Слайд 18Чувствительность к АМ препаратам:
Пенициллин
Эритромицин
Хлорамфеникол
Гентамицин
Стрептомицин
Тетрациклин
Слайд 19Лечение:
Введение антитоксической противодифтерийной сыворотки, не дожидаясь результатов микробиологического анализа.
Слайд 20 Действующее начало всех вакцин –
дифтерийный анатоксин (дифтерийный гистотоксин, утративший токсичность, но сохранивший антигенные свойства
в результате обработки формалином при 37-40С в течение 4 недель:АД – адсорбированный дифтерийный анатоксин
АДС – адсорбированный дифтерийно-столбнячный анатоксин
АДС-М анатоксин -вакцина для профилактики дифтерии и столбняка с уменьшенным содержанием антигенов
АД-М анатоксин вакцина для профилактики дифтерии с уменьшенным содержанием антигенов
Имовакс Д.Т. Адюльт вакцина для профилактики дифтерии и столбняка, аналог АДС-М (Aventis Pasteur, Франция)
ДТ Вакс вакцина для профилактики дифтерии и столбняка, аналог АДС (Aventis Pasteur, Франция)
Специфическая профилактика
Слайд 21Специфическая профилактика
ТетрАкт-ХИБ
Адсорбированная вакцина против дифтерии, столбняка, коклюша и гемофильной инфекции
типа b (Франция)
Тританрикс
вакцина для профилактики коклюша, дифтерии, столбняка и
гепатита В
(Бельгия)Тетракок 05 вакцина для профилактики коклюша, дифтерии, столбняка и полиомиелита (Франция)
Инфанрикс бесклеточная вакцина для профилактики коклюша, дифтерии и столбняка (Бельгия)
Пентаксим Вакцина для профилактики дифтерии и столбняка адсорбированная, коклюша ацеллюлярная, полиомиелита инактивированная, инфекции, вызываемой Haemophilus influenzae тип b конъюгированная.
АКДС – адсорбированная коклюшно-дифтерийно-столбнячная вакцина
Слайд 22 Проба Шика проводится для оценки состояния антитоксического иммунитета;
внутрикожно
вводят минимальное количество токсина:
При наличии антител против дифтерийного токсина видимых
изменений не будетПри отсутствии антитоксического иммунитета наблюдается воспалительная реакция
Слайд 23Коклюш – острое инфекционное высококонтагиозное заболевание, характеризующееся приступами судорожного кашля.
Bordetella pertussis
По данным ВОЗ, в мире ежегодно заболевает коклюшем около
60 млн человек, умирает около 1 млн детей, преимущественно в возрасте до одного года.Слайд 24Возбудитель коклюша – был
открыт в 1906г. Ж.Борде и О.Жангу
Жюль
Борде
Jules Bordet (1870-1961) –
Нобелевская премия по
медицине 1919г.
Octave Gengou
(1875-1957)Нобелевская премия по
физиологии и медицине 1919г.
Слайд 26Морфология
Мелкая, овоидная, грам- палочка с закругленными концами
Неподвижны. Спор нет.
Жгутиков нет. Образует капсулу, пили.
Слайд 27Резистентность
Очень неустойчива во внешней среде. Быстро разрушается под действием
дезинфектантов, антисептиков , чувствительны к солнечному излучению. При 50-55°С погибают
за 30 мин., при кипячении - мгновенно.Антигенные свойства
О-Аг
К-Аг, состоящий из 14 компонентов (агглютиногены).
7 компонент - общий для всех бордетелл
Обязательными для B.pertussis являются 1 и 7 компоненты.
Слайд 31
Адгезия
Филаментозный гемагглютинин -крупный белок, образующий филаментозные структуры на поверхности бактериальной
клетки
Обеспечивает адгезию, связываясь с галактозными остатками сульфогликолипида на поверхности ресничного
эпителияСлайд 32
Агглютиногены тесно связаны с белками фимбрий
Иммунизация фимбриальными белками защищает от
аэрозольного заражения
Различия в структуре фимбриальных белков позволяют м/о избежать воздействия
АТПертактин и ряд других поверхностных белков участвуют в адгезии, взаимодействуя с белками-рецепторами из семейства интегринов на поверхности клеток человека
Белок BrkA (Bordetella resistance to killing) участвует в адгезии, инвазии и обеспечивает устойчивость бактерии к классическому комплемент-зависимому пути элиминации антигенов
Слайд 33Токсины Bordetella pertussis
Аденилатциклаза – единый полипептид , который может
быть связан с клеткой и выделяться в окружающую среду
Состоит из
двух субъединиц: отвечающей за ферментативную активность и за связывание с рецепторами клетокВпервые был обнаружен как гемолизин
Активен только в клетках эукариот
Накопление цАМФ нарушает структру и физиологию клетки (аналогичен токсину В. anthracis)
Слайд 34Приводит к накоплению нейтрофилов в жидкости и снижению количества альвеолярных
макрофагов в результате их апоптоза
Играет роль на начальном этапе развития
инфекцииМутанты по аденилатциклазе могут колонизировать слизистую, но обладают сниженной вирулентностью
Дерматонекротический токсин
В пораженных клетках развивается ряд характерных явлений: складчатость мембраны, фокальная адгезия и напряженные актиновые волокна, а также ДНК-репликация без клеточного деления
гомологичен цитотоксину E.coli
Роль в патогенезе коклюша неясна
Слайд 35Трахеальный цитотоксин
- фрагмент пептидогликана клеточной стенки
Повреждает ресничный эпителий и вызывает
цилиостаз – нарушается отток слизи и создаются условия для персистирования
возбудителяСтимулирует продукцию ИЛ-1, в ответ на который синтезируется оксид азота
Обладает таким свойством, как пирогенность
Слайд 36Липополисахарид
Отличается от ЛПС энтеробактерий
липид определяет биологическую активность (пирогенность, токсичность, адъювантность,
стимуляцию продукции ИЛ-1)
В целом, ЛПС обладает иммуногенностью
С ним связывают реактогенность
цельноклеточной коклюшной вакциныСлайд 37Коклюшный токсин
Опосредует как стадию колонизации, так и токсемическую стадию
- белок
с АВ5 структурой:
Участок В – 5 субъединиц S2- S5,
отвечает за связывание с рецепторами клеток-мишенейучасток А соответствует субъединице S1, обладает ферментативной активностью – осуществляет АДФ-рибозилирование G-белка, ингибирующего в норме аденилатциклазу
Слайд 38Накопление цАМФ приводит к:
Подавлению всех стадий фагоцитоза,
Нарушению нормального расселения лимфоцитов
(«хоуминг-эффект»),
Опустошению тимус-зависимых зон лимфоидной ткани,
Действует на клетки поджелудочной железы, вызывая
гиперпродукцию инсулина и как следствие-гипогликемиюУсиливает чувствительность к гистамину (в результате - увеличение проницаемости капилляров, гипотензия, шок)
Слайд 39У современных штаммов B.pertussis произошли существенные изменения в структуре ptxA
гена, кодирующего S1 субъединицу коклюшного токсина, prn гена, кодирующего пертактин,
и в фимбриальном fim3 гене, кодирующем Fim3 белок.Штаммы B.pertussis, характеризующиеся новыми «невакцинными» аллелями генов патогенности, обладают высокой степенью вирулентности
Эти штаммы полностью вытеснили "старые" штаммы.
Слайд 40Коклюш - высококонтагиозное заболевание, к которому очень восприимчивы дети (у
взрослых вызывает затяжной бронхит)
Источник инфекции – больной (заразен до
25-30дн) или бактерионосительПуть передачи - воздушно-капельный
Периоды заболевания:
инкубационный(5-8дн, до14)
катаральный (5-14дней)
судорожный (пароксизмальный) (2-8 недель)
период разрешения (2-4 недели)
ЛЕЧЕНИЕ: симптоматическое;
антибиотикотерапия показана до пароксизмального периода
Слайд 41Лабораторная диагностика
Клинический материал собирают
- сухим тампоном с задней
стенки глотки и делают посев на питательные среды
- методом
кашлевых пластинокСлайд 42Бактериологический метод
Цель бактериологического исследования:
Выделение чистой культуры и идентификация возбудителя
коклюша
Дифференциальный анализ культуральных свойств возбудителей коклюша (B.pertussis) и паракоклюша (B.parapertussis)
1 этап: Посев на следующие питательные среды:картофельно-глицериновый агар Борде,
казеиновый-угольный агар, кровяной агар
2 этап:
Палочки коклюша через 48-72 ч роста образуют мелкие блестящие колонии серого цвета
Паракоклюшные палочки через 24-48 ч роста образуют колонии несколько крупнее
Слайд 43Питательные среды для культивирования бордетелл
Среда Борде-Жангу (картофельно-глицериновый агар с кровью)
Среда
КУА (казеиново-угольный агар)
Оптимальная t культивирования 37°С при рН 7,2.
Не
растет на простых питательных средах, культивируется на картофельно-глицериновом агаре и на полусинтетическом казеиново-угольном агаре без добавления крови. Слайд 46Чувствительность к антимикробным препаратам
Эритромицин
Ампициллин
Профилактика - Вакцинация:
1- 3 мес
2- 4
мес
3 – 5 мес
4- 18 мес
В 6, 11, 16 лет,
каждые 10 летСлайд 48Ацеллюлярные вакцины
Компоненты B.pertussis :филаментозный гемагглютинин, пертактин, фимбрии, анатоксин
коклюшного токсина
Современная вакцина
АКаДС включает неклеточный коклюшный компонент
Инфаринкс (Бельгия):
3 компонента (против коклюша,
дифтерии, столбняка) +1 компонент (против Хиб-инфекции – «Хиберикс»)
Слайд 49Название заболевания связано со вспышкой 1976 г в Филадельфии тяжёлого респираторного заболевания, протекавшего по
типу пневмонии. В июле 1976 г более 4000 участников съезда Американского легиона собралось в Филадельфии
(штат Пенсильвания, США). Всего же во время этой вспышки заболел 221 человек, из них 34 скончалось.Легионеллез
Legionella pneumophila
Слайд 50Особенности экологии легионелл и их роль в
эпидемиологии легионеллеза
Вектор эпидемической
значимости
некультивируемое состояние
внутриклеточное
размножение
в амебах
образование
биопленок на
синтетических,
резиновых,
металлических,
поверхностях
Высокие адаптивные способности микроорганизма
Широкое распространение и выживание
легионелл в природных условияхСимбиоз с цианобактериями и сине-зелеными водорослями
Выживание в трофозоитах и цистах простейших (амебы)
Способность вызывать сочетанную патологию с другими патогенами респираторного тракта (аденовирусы, вирус гриппа В, микоплазмы)
Слайд 54Фактроры риска:
Лица, старше 60 лет
Длительно курящие
Алкоголики
Иммунодефициты: первичные и вторичные (онкобольные,
ВИЧ-инфицированные)
Предшествующие заболевания: диабет, ОПН на диализе, хронические болезни легких
Лица, длительно
получающие кортикостероиды и иммунодепрессантыИнтенсивная терапия аэрозолями
Слайд 57Синуситы
Целлюлиты
Перитониты
Пиелонефриты
Панкреотиты
Раневые инфекции
Лимфааденопатии
Миокардиты
Перикардиты
Эндокардиты искуственных клапанов
Посткардиотомический синдром
Экстрапульмональные проявления легионеллеза
Слайд 58Предупреждение госпитального инфицирования
Использование стерильной воды для небулайзеров и оборудования для
неинвазивной вентиляции легких
Стоматологи должны использовать стерильную воду в процессе работы
Не использовать увлажнители воздуха, создающие аэрозоли, без их стерилизации, ежедневной дезинфекции и заполнять их стерильной водой
Ограничивать пациентов с иммунодефицитами от приема душа
Использовать стерильную воду для питья и приема лекарств
При необходимости принятия душа ежемесячно чистить и дезинфицировать душевую установку